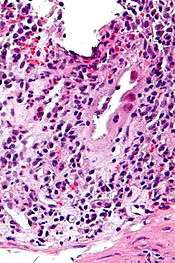

Cytomegalovirus colitis
| Cytomegalovirus colitis | |
|---|---|
![]() | |
| Micrograph of CMV colitis. H&E stain. | |
| Classification and external resources |
Cytomegalovirus colitis, also known as CMV colitis, is an inflammation of the colon
Causes The infection is spread by saliva, urine, respiratory droplets, sexual contact, and blood transfusions. Most people are exposed to the virus in their lifetime, but it usually produces mild or no symptoms in healthy people.
However, serious CMV infections can occur in people with weakened immune systems. This includes patients receiving chemotherapy for cancer and patients on immune-suppressing medicines following an organ transplant.
In rare instances, more severe CMV infection involving the GI tract has been reported in people with a healthy immune system.
Diagnosis
The diagnosis of CMV colitis is based on serology, CMV antigen testing and colonscopy with biopsy. Clinical suspicion should be aroused in the setting of immunocompromised patient but it is much rarer in immunocompetent patient. Although it is known that CMV colitis is almost always caused by reactivation of latent CMV infection in immunocompromised patients, new infection of CMV or reinfection of different strain of CMV can cause colitis in immunocompetent hosts. Because asymptomatic CMV viremia and viruria is common and about 1/3 of symptomatic CMV infection is caused by reinfection of different strain of CMV, the diagnosis of CMV colitis needs more direct causality. It is practically achieved by colonoscopy or sigmoidoscopy tissue sampling and pathological evidence of CMV infection under microscope. Positive CMV IgG doesn't necessarily mean that it is reactivation of latent infection because of the possibility of reinfection of different strain.
Treatment
The usual treatment is antivirals, specifically ganciclovir or valganciclovir.[1] Severe CMV colitis may lead a colectomy.[2]
Risk factors
The systemic use of corticosteroids in the context of inflammatory bowel disease.[1]
References
- 1 2 Kandiel A, Lashner B (December 2006). "Cytomegalovirus colitis complicating inflammatory bowel disease". Am. J. Gastroenterol. 101 (12): 2857–65. doi:10.1111/j.1572-0241.2006.00869.x. PMID 17026558.
- ↑ Lawlor G, Moss AC (September 2010). "Cytomegalovirus in inflammatory bowel disease: pathogen or innocent bystander?". Inflamm. Bowel Dis. 16 (9): 1620–7. doi:10.1002/ibd.21275. PMID 20232408.